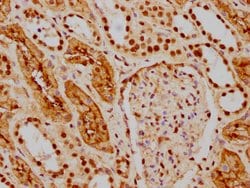
Invitrogen HDAC9 Recombinant Rabbit Monoclonal Antibody (1F2) 100 &mu;L | Buy Online | Invitrogen&trade; | Fisher Scientific

Learn More
Invitrogen™ HDAC9 Recombinant Rabbit Monoclonal Antibody (1F2)


Description
HDAC9 Recombinant Monoclonal Antibody for ELISA, ICC/IF, IHC (P), Western Blot

Specifications
Specifications
| Antigen | HDAC9 |
| Applications | ELISA, Immunohistochemistry (Paraffin), Western Blot, Immunocytochemistry |
| Classification | Recombinant Monoclonal |
| Clone | 1F2 |
| Concentration | 1.49 mg/mL |
| Conjugate | Unconjugated |
| Formulation | PBS with 50% glycerol and 0.02% sodium azide; pH 7.4 |
| Gene | Hdac9 |
| Gene Accession No. | Q9UKV0 |
| Gene Alias | AV022454; D030072B18Rik; DKFZp779K1053; HD7; HD7b; HD9; HDAC; HDAC7; Hdac7b; HDAC9; hdac-9; HDAC9B; HDAC9FL; HDRP; histone deacetylase 4/5-related protein; histone deacetylase 7B; Histone deacetylase 9; histone deacetylase-related protein; KIAA0744; MEF-2 interacting transcription repressor (MITR) protein; MEF2-interacting transcription repressor MITR; Mitr; mKIAA0744; RGD1310748; RGD1563092; TWIST |
| Show More |
By clicking Submit, you acknowledge that you may be contacted by Fisher Scientific in regards to the feedback you have provided in this form. We will not share your information for any other purposes. All contact information provided shall also be maintained in accordance with our Privacy Policy.